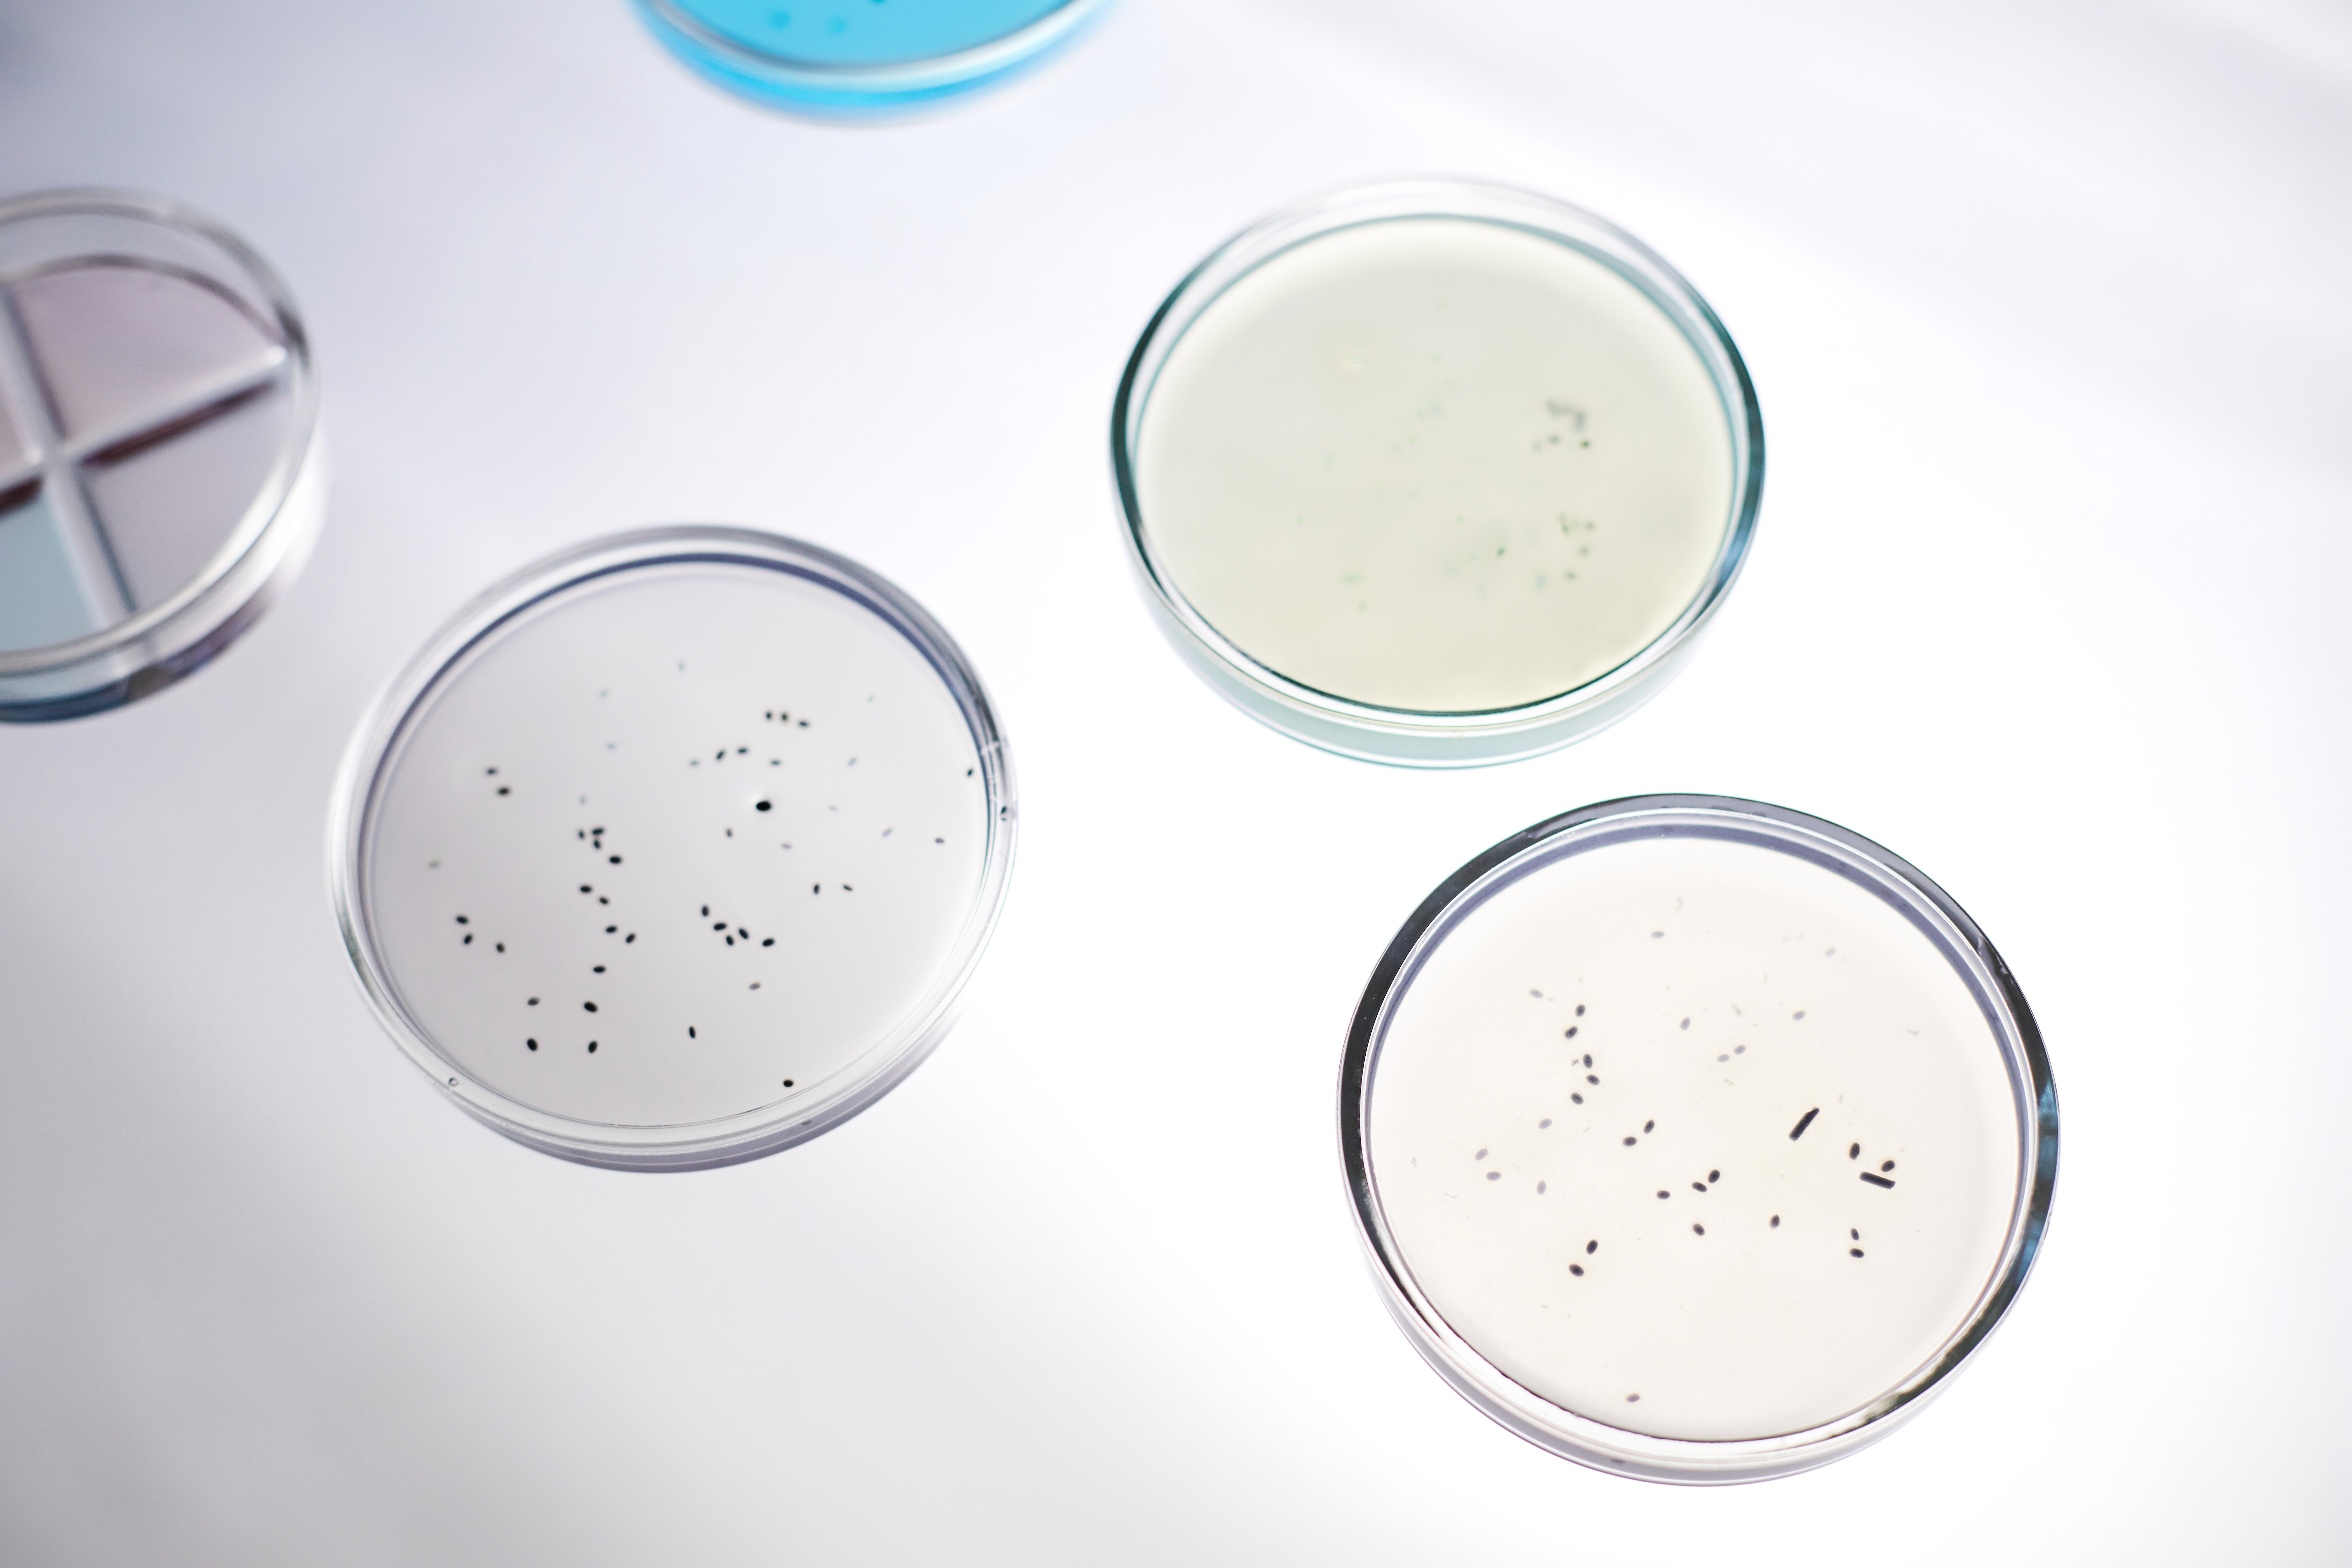
The image featured in the middle of the about us page

Detergents
regulatory
regulatory
Pharmilabprovidestechnicalandregulatorysupportinthedevelopmentandmarketplacementofdetergents,ensuringcompliancewithRegulation(EC)No.648/2004andotherapplicablerequirements.
Pharmilabisahighlyexperiencedproviderofcompletesolutionsforthedevelopment,regulation,andmarketplacementofcosmeticproducts,guaranteeinglegalcomplianceandqualityateverystep.
Pharmilabprovidestechnicalandregulatorysupportinthedevelopmentandmarketplacementofdetergents,ensuringcompliancewithRegulation(EC)No.648/2004andotherapplicablerequirements.
Weoverseetheentireprocess,fromformulationandlabellingtothepreparationoftechnicalandsafetydatasheets,ensuringproductsthataresafe,effective,andlegallycompliant.
Fromformulationtolabelling,includingsafetyassessmentandregulatorysubmissions,weoverseeeverystepwithscientificrigorandup-to-dateindustryknowledge.
Weoverseetheentireprocess,fromformulationandlabellingtothepreparationoftechnicalandsafetydatasheets,ensuringproductsthataresafe,effective,andlegallycompliant.


Placing a detergent in EU/UK
Microbiology and Physicochemicals
Before placing detergents on the EU or UK markets, manufacturers must ensure compliance with several mandatory legislative acts. The primary requirements include Regulation (EC) No 648/2004 on detergents and Regulation (EC) No 1272/2008 on classification and labelling, alongside the REACH Regulation. Depending on the product's specific composition and intended use, additional rules regarding biocidal products or phosphorus compounds may also apply.
Beyond legal obligations, responsible brands are expected to adhere to good industry practices, such as guidelines from the A.I.S.E. and IFRA standards regarding fragrance safety. Companies wishing to demonstrate further commitment to sustainability can also pursue voluntary initiatives like the Ecolabel certification, which recognizes products that meet high environmental standards throughout their life cycle.
Before placing detergents on the EU or UK markets, manufacturers must ensure compliance with several mandatory legislative acts. The primary requirements include Regulation (EC) No 648/2004 on detergents and Regulation (EC) No 1272/2008 on classification and labelling, alongside the REACH Regulation. Depending on the product's specific composition and intended use, additional rules regarding biocidal products or phosphorus compounds may also apply.
Beyond legal obligations, responsible brands are expected to adhere to good industry practices, such as guidelines from the A.I.S.E. and IFRA standards regarding fragrance safety. Companies wishing to demonstrate further commitment to sustainability can also pursue voluntary initiatives like the Ecolabel certification, which recognizes products that meet high environmental standards throughout their life cycle.
Before placing detergents on the EU or UK markets, manufacturers must ensure compliance with several mandatory legislative acts.
The primary requirements include Regulation (EC) No 648/2004 on detergents and Regulation (EC) No 1272/2008 on classification and labelling, alongside the REACH Regulation.
Depending on the product's specific composition and intended use, additional rules regarding biocidal products or phosphorus compounds may also apply.
Beyond legal obligations, responsible brands are expected to adhere to good industry practices, such as guidelines from the A.I.S.E. and IFRA standards regarding fragrance safety.
Companies wishing to demonstrate further commitment to sustainability can also pursue voluntary initiatives like the Ecolabel certification, which recognizes products that meet high environmental standards throughout their life cycle.
Range of services
Mutual Recognition in the EU
Pharmilab provides end-to-end regulatory support for detergents, from formula audits and ingredient reviews to product classification and Material Safety Data Sheet (MSDS) creation. We ensure compliance through biodegradability assessment, toxicological risk analysis (A.I.S.E. guidelines), and comprehensive checks of finished products, labels, and marketing claims. Additionally, we handle specialized requirements such as biocidal regulation compliance and poison center notifications.
Pharmilab provides end-to-end regulatory support for detergents, from formula audits and ingredient reviews to product classification and Material Safety Data Sheet (MSDS) creation. We ensure compliance through biodegradability assessment, toxicological risk analysis (A.I.S.E. guidelines), and comprehensive checks of finished products, labels, and marketing claims. Additionally, we handle specialized requirements such as biocidal regulation compliance and poison center notifications.
Pharmilab provides end-to-end regulatory support for detergents, from formula audits and ingredient reviews to product classification and Material Safety Data Sheet (MSDS) creation. We ensure compliance through biodegradability assessment, toxicological risk analysis (A.I.S.E. guidelines), and comprehensive checks of finished products, labels, and marketing claims. Additionally, we handle specialized requirements such as biocidal regulation compliance and poison center notifications.

REACH services
Request for assignment of a National Product Code (CNP)
REACH’s registration obligations are based on two fundamental principles. Each substance imported or manufactured in Europe must be registered, but only once. If a single entity is responsible for more than one tonne per year of a substance, it shall record that substance. Where a product (including cosmetics) is imported into Europe, the quantities of each substance must be calculated and the entity responsible for them must be identified.
Pharmilab offers a complete audit service to help you calculate substance quantities, identify your specific legal obligations, and ensure proper communication throughout your supply chain.
REACH’s registration obligations are based on two fundamental principles. Each substance imported or manufactured in Europe must be registered, but only once. If a single entity is responsible for more than one tonne per year of a substance, it shall record that substance. Where a product (including cosmetics) is imported into Europe, the quantities of each substance must be calculated and the entity responsible for them must be identified.
Pharmilab offers a complete audit service to help you calculate substance quantities, identify your specific legal obligations, and ensure proper communication throughout your supply chain.
REACH’s registration obligations are based on two fundamental principles. Each substance imported or manufactured in Europe must be registered, but only once. If a single entity is responsible for more than one tonne per year of a substance, it shall record that substance. Where a product (including cosmetics) is imported into Europe, the quantities of each substance must be calculated and the entity responsible for them must be identified.
Pharmilab offers a complete audit service to help you calculate substance quantities, identify your specific legal obligations, and ensure proper communication throughout your supply chain.
We help you
We help you
We help you
· Identify of your substances of interest
· Reach status investigation
· Assess potential regulatory actions
· Represent to the partner groups
· Identify of your substances of interest
· Reach status investigation
· Assess potential regulatory actions
· Represent to the partner groups
· Identify of your substances of interest
· Reach status investigation
· Assess potential regulatory actions
· Represent to the partner groups

CLP Regulation (Classification, Labelling and Packaging)
Labeling
EU legislation that adopts the United Nations' Global Harmonised System (GHS). It requires all manufacturers, importers, and downstream users to accurately classify, label, and package hazardous substances and mixtures before placing them on the market. This ensures that hazards are clearly identified and communicated to consumers and workers throughout the supply chain.
Pharmilab offers expert guidance across these areas:
Classification: Analyzing technical data to identify physical, health, or environmental hazards (including self-classification or harmonized classification).
Labelling: ensuring labels meet specific content and safety standards (e.g., child safety closures, tactile warnings).
Safety Data Sheets (SDS): Creating compliant SDS (and extended SDS for large volumes) to inform professional users of risks.
Notifications: Handling mandatory submissions to the Classification and Labelling Inventory and Antivenom Centres (Poison Centres) for emergency response.
CLH Dossiers: Preparing dossiers for high-concern substances (like carcinogens or pesticides) for ECHA evaluation.
EU legislation that adopts the United Nations' Global Harmonised System (GHS). It requires all manufacturers, importers, and downstream users to accurately classify, label, and package hazardous substances and mixtures before placing them on the market. This ensures that hazards are clearly identified and communicated to consumers and workers throughout the supply chain.
Pharmilab offers expert guidance across these areas:
Classification: Analyzing technical data to identify physical, health, or environmental hazards (including self-classification or harmonized classification).
Labelling: ensuring labels meet specific content and safety standards (e.g., child safety closures, tactile warnings).
Safety Data Sheets (SDS): Creating compliant SDS (and extended SDS for large volumes) to inform professional users of risks.
Notifications: Handling mandatory submissions to the Classification and Labelling Inventory and Antivenom Centres (Poison Centres) for emergency response.
CLH Dossiers: Preparing dossiers for high-concern substances (like carcinogens or pesticides) for ECHA evaluation.
EU legislation that adopts the United Nations' Global Harmonised System (GHS). It requires all manufacturers, importers, and downstream users to accurately classify, label, and package hazardous substances and mixtures before placing them on the market. This ensures that hazards are clearly identified and communicated to consumers and workers throughout the supply chain.
Pharmilab offers expert guidance across these areas:
Classification: Analyzing technical data to identify physical, health, or environmental hazards (including self-classification or harmonized classification).
Labelling: ensuring labels meet specific content and safety standards (e.g., child safety closures, tactile warnings).
Safety Data Sheets (SDS): Creating compliant SDS (and extended SDS for large volumes) to inform professional users of risks.
Notifications: Handling mandatory submissions to the Classification and Labelling Inventory and Antivenom Centres (Poison Centres) for emergency response.
CLH Dossiers: Preparing dossiers for high-concern substances (like carcinogens or pesticides) for ECHA evaluation.
Conquer the world
with your brand
Fill out the form today and experience expert services

Conquer the world
with your brand
Fill out the form today and experience expert services

Conquer the world
with your brand
Fill out the form today and experience expert services
